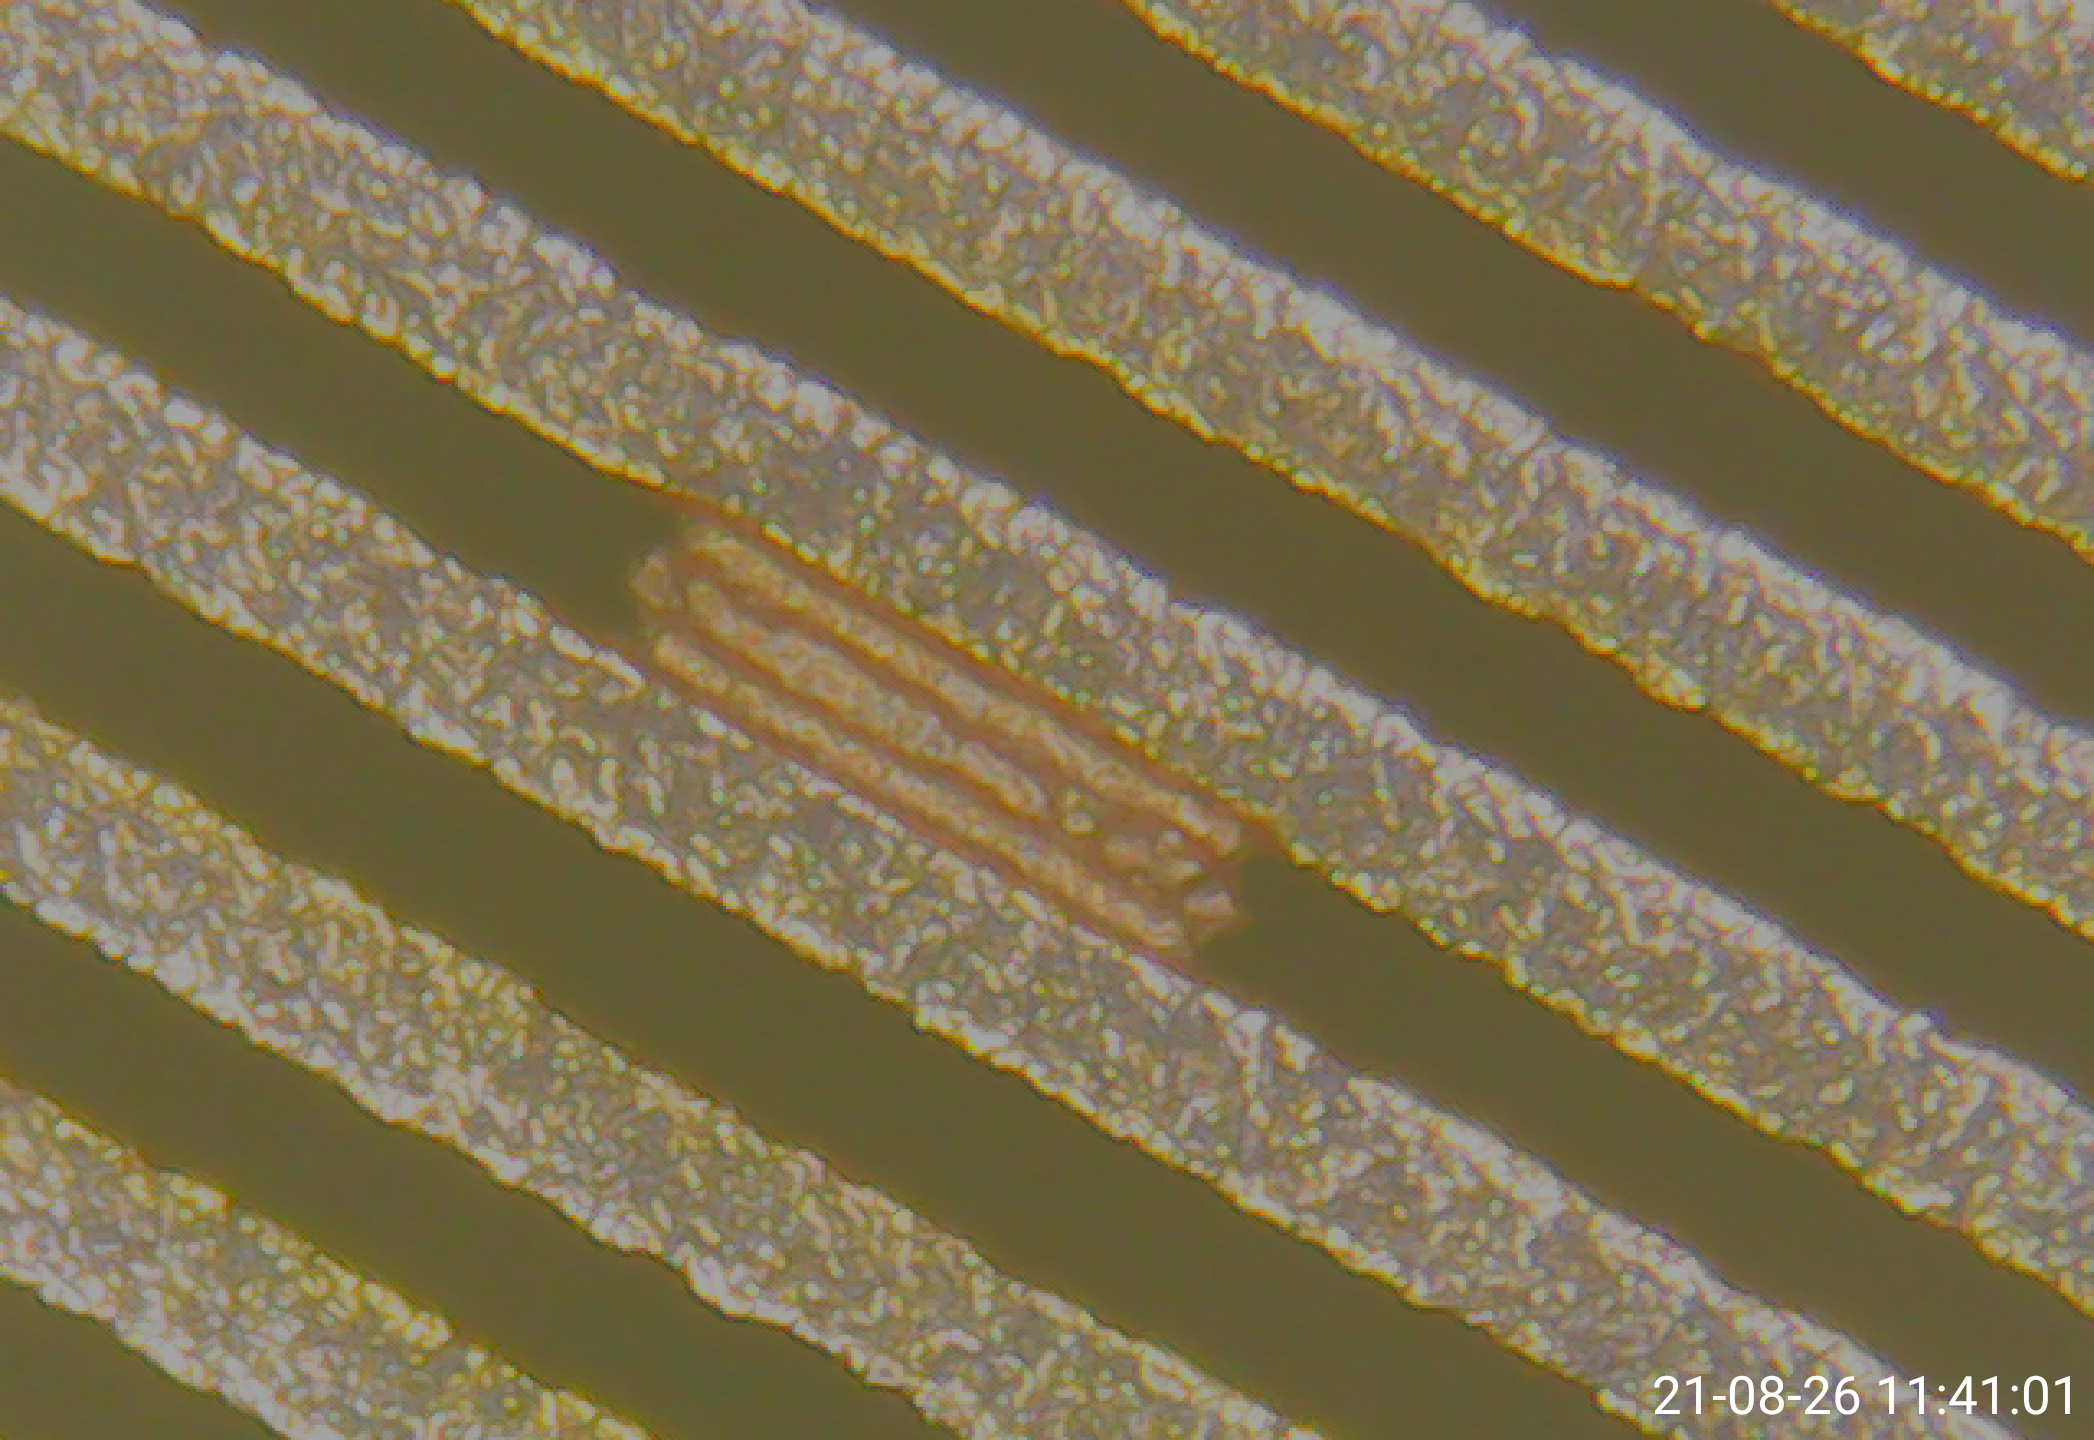
PCB, curto ,  sobra de cobre PCB

SERVIÇOS REALIZADOS:
A Alfacleaner realiza para seus clientes e também para montadoras de placas de circuito impresso análises metalográficas, a fim de verificar possíveis problemas de continuidade da placa, blow hole, falha de metalização, camada de cobre depositada, etc.
Todos os clientes que utilizam os produtos da Alfacleaner possuem um suporte técnico e de laboratório físico e químico para análises dos banhos das linhas, avaliação metalográfica periódica a fim de avaliar o processo e corrigir eventuais problemas durante a fabricação das placas de circuito impresso.
SERVIÇOS REALIZADOS EM CLIENTES (FABRICANTES DE PLACAS):
- Auditoria de processo
- Análise de falhas
- Medição de camada de cobre depositada
- Ajuste de parâmetros de processo
- Cortes metalográficos para identificar problemas de processo e qualidade
- Análise dos banhos fornecidos pela Alfacleaner

SERVIÇOS REALIZADOS EM MONTADORAS DE PLACAS:
- Análise de falhas em placas montadas
- Análise de falhas em placas nuas
- Medições de camada de cobre depositado
- Análise de qualidade da placa (Camada de cobre, camada de máscara de solda, camada de estanho)
- Análise para identificar problemas de continuidade elétrica
- Análise metalográfica






















